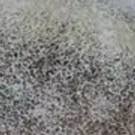

Produits similaires
Produits similaires

Couleur
Crème
Livraison et politiques
- Date de livraison estimée : 26 janv.–4 févr.
Retours gratuits et faciles. En savoir plus
Achetez des produits B2B uniques pour votre magasin sur Faire auprès de marques telles que Studio Lowen et bien plus encore.
Description
Ne perdez jamais vos clés avec ce porte-clés en cuir pratique, accrochez-les dès que vous rentrez chez vous. Disponible dans une gamme de belles couleurs de cuir, il y en a pour tous les goûts. Le porte-clés en cuir est disponible dans une gamme de couleurs. Choisissez parmi de nombreuses couleurs magnifiques, y compris : * Jaune Moutarde * Cuivre Métallique * Rouge Coquelicot * Rouge Métallique * Rose Bébé * Rose Métallique * Framboise * Baie Métallique * Verre de Mer * Bleu Poudre * Diamant Métallique * Bleu Marine Métallique * Olive * Bleu Atlantique * Vert Pin * Crème * Noir Vous cherchez nos métalliques scintillants ? Ceux-ci sont listés séparément.
Ce texte a été traduit automatiquement.
Détails
Pays de fabrication : Royaume-Uni
Plus d'articles de cette marque
Plus d'articles de cette marque
Plus d'articles de cette marque
Plus d'articles de cette marque
Tout afficherÉvaluations et avis
Pertinence
Top Shop met à l'honneur les marques exceptionnelles qui ont obtenu une note de plus de 4,8 au cours des 12 derniers mois, traitent les commandes rapidement et sans erreur et proposent un catalogue à jour.
4,9
Note de la marque ()
5
5
36
36
4
4
2
2
3
3
0
0
2
2
0
0
1
1
0
0
5,0
Qualité des produits
5,0
Traitement
5,0
Communication
Le produit Porte-clés à boucle en cuir n'a pas encore reçu d'avis.